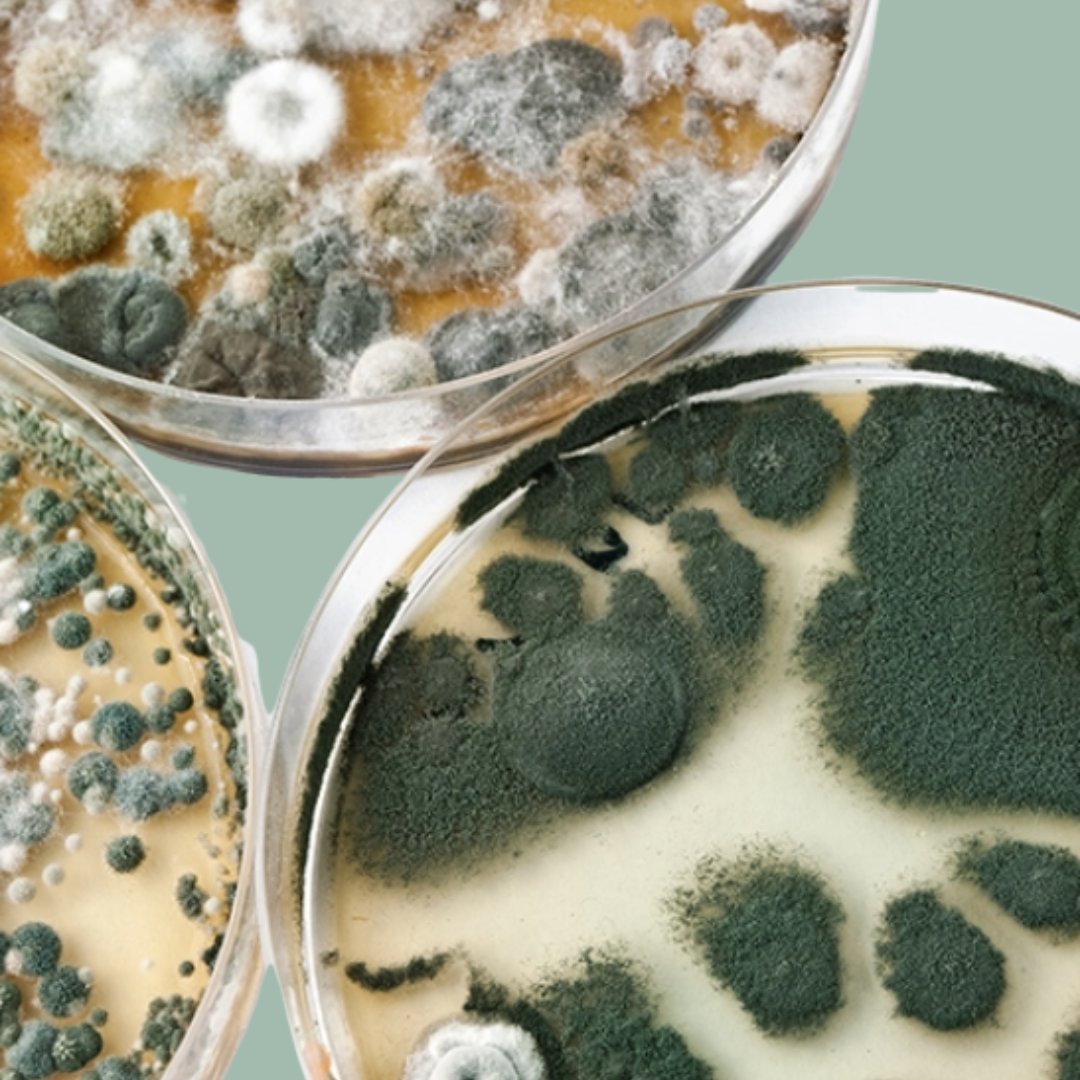
Mold

Founded by a Functional Medicine Practitioner
Evan Brand: The Vision Behind Aura Roots
Aura Roots was created by Evan Brand, a Board-Certified Holistic Nutritionist and Functional Nutritional Therapy Practitioner. After overcoming his own struggles with mold toxicity, gut infections, and hormone imbalances, Evan dedicated his career to helping others restore their health through his Functional Medicine Clinic. Every Aura Roots formula is inspired by his clinical experience with thousands of clients, blending nature’s wisdom with science-backed solutions to deliver supplements that are pure, powerful, and designed for real results.